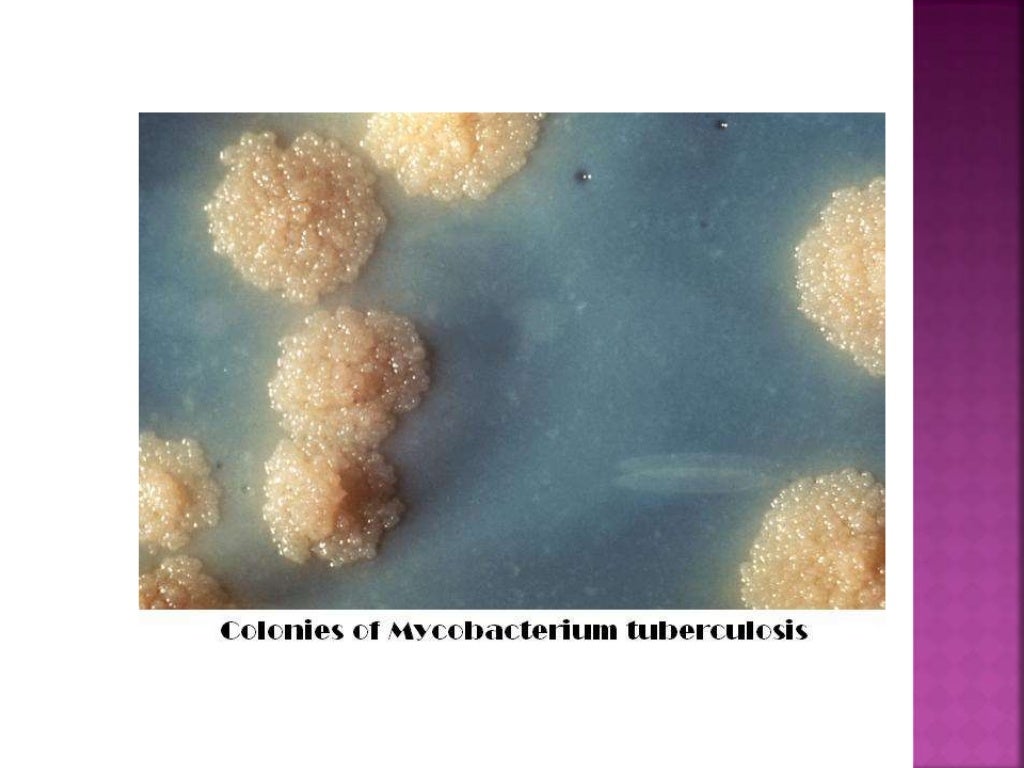

This is a false positive when that happens.

Note: Some security programs may flag the program as malicious. In addition to that, it uses barely any cpu cycles when running. How lightweight? It uses less than 2 Megabytes of memory when it is running and when you don't interact with the program in any way. What you may like about it is that it is open source, portable, and pretty lightweight. TranslucentTB is a standalone program that offers the same functionality. While functionality changed - you can pin programs to the taskbar, and use new features like jumplists as well - appearance options have not changed all that much.īack in 2015 I reviewed a new version of the popular application Classic Shell which shipped with functionality to make the Windows taskbar transparent. If cookie is disabled you'll see the site in the original language.The Windows Taskbar is one of the central locations to start and manage programs on Windows ever since Microsoft improved its functionality with the release of Windows 7. Cookie we use to offer you the possibility to switch the language of our contents. If cookie is disabled you'll see the site in the original language. If deactivated, the default store currency will be displayed.Ĭookie we use to offer you the possibility to switch the language of our contents. Cookie that allows you to choose the currency you want to see the prices of our products. If deactivated, the default store currency will be displayed. If disabled the store default currency will be shown.Ĭookie that allows you to choose the currency you want to see the prices of our products. Cookie which makes possible to choose the currency you would like. If disabled the store default currency will be shown. NameĬookie which makes possible to choose the currency you would like. Preference cookies enable a website to remember information that changes the way the website behaves or looks, like your preferred language or the region that you are in.
